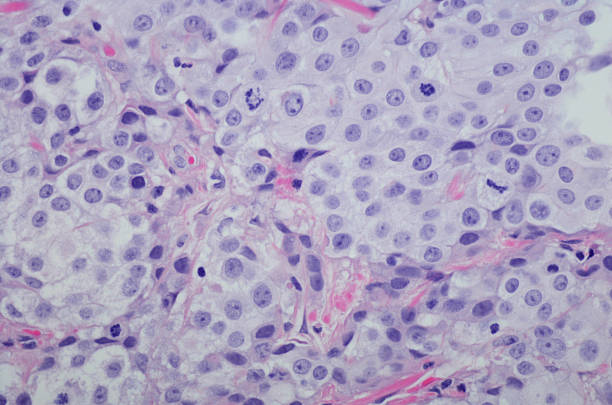

방광암 초기증상 10가지 자세히 알아보기

방광암은 초기에 증상이 뚜렷하지 않아서, 발견되기 전까지 오랜 기간 동안 증상이 없을 수 있습니다. 이로 인해 진단이 늦어져 치료가 어려워질 수 있습니다. 그러므로, 방광암의 초기증상을 잘 알고 있어야 증상이 나타났을 때 빠르게 대처할 수 있으며, 조기 발견과 치료로 인한 예후 개선 가능성이 큽니다. 또한 방광암은 흡연, 화학 물질 노출, 방광염 등의 위험 요인에 노출되면 발생할 가능성이 높습니다. 따라서 위험 요인에 노출되는 직업이나 환경에서 근무하는 사람들은 방광암에 대한 예방과 조기 발견에 더욱 신경써야 합니다.
자주 볼때마다 소변량이 적다는 느낌이 드는 경우



방광암이 초기단계에서는 방광 내부에 종양이 형성되어 있을 수 있으며, 종양이 방광의 용량을 차지하여 소변의 양이 감소하게 됩니다. 이로 인해 소변을 보고나서도 만족스럽게 소변이 나오지 않는 느낌이 들 수 있습니다. 소변량의 변화는 개인마다 다를 수 있으며, 소변량의 감소가 지속된다면 의사를 찾아 상세한 검진을 받아야 합니다.
소변이 희고 투명하지 않고 탁해지거나 혼탁해진 경우



방광암이 발생하면 종양이 방광 내부에 있어 소변과 직접 접촉하게 되어 소변이 희고 탁해지거나 혼탁해질 수 있습니다. 소변이 투명하지 않고 탁해지는 것은 방광 내부의 종양이 성장하고 있는 것을 나타낼 수 있습니다. 이러한 증상이 지속되면 의사를 찾아 검진을 받아야 합니다.
소변에 섞인 혈뇨나 핏물이 나오는 경우



방광암의 초기증상 중 하나로 소변에 섞인 혈뇨나 핏물이 나오는 경우가 있습니다. 방광 내부의 종양이 소변에 혈관을 침범하여 혈뇨가 발생할 수 있습니다. 소변에 섞인 혈뇨나 핏물이 나오는 경우에는 의사를 찾아 상세한 검진을 받아야 합니다. 이러한 혈뇨나 핏물이 지속되는 경우 진단과 치료를 위해 빠른 시일 내에 의료 전문가의 조언을 받아야 합니다.
소변을 보는데 어려움이 있는 경우



방광암 초기증상으로 소변을 보는데 어려움이 있는 경우는 드물지만 발생할 수 있습니다. 방광암이 발생하면 방광벽에 종양이 생겨서 방광의 용량이 감소하게 됩니다. 이 경우 소변이 자주 나오지만 소량씩 방출되거나 소변을 가누기가 어려워질 수 있습니다. 소변을 보는데 어려움이 생긴다면 방광암 가능성이 있으므로 즉시 전문의를 방문하는 것이 좋습니다.
복부에 압통이나 불편감이 있는 경우



방광암 초기증상으로 복부에 압통이나 불편감이 있는 경우는 비교적 더 자주 발생합니다. 이는 종양이 방광 벽을 침범하고 근육을 늘리거나 복강 내 다른 기관에 영향을 미치면서 생길 수 있습니다. 이러한 증상은 방광암 이외에도 다른 병인에서도 나타날 수 있으므로 반드시 전문의의 진단을 받아야 합니다.
하지나 발목 부근의 부종이 나타나는 경우



방광암 초기증상으로 하지나 발목 부근의 부종이 나타나는 경우는 드물게 발생합니다. 이는 방광암이 진행되면서 림프관에 침범하여 림프절에 암세포가 전이되어 생길 수 있습니다. 따라서 부종이 나타난다면 즉시 전문의의 진료를 받는 것이 중요합니다.
소변을 보는데 어려움을 느끼는 경우



방광암 초기증상으로 소변을 보는데 어려움을 느끼는 경우는 일반적으로 방광암이 방광의 출구를 막거나 방광벽을 침범한 경우 발생합니다. 이로 인해 소변이 충분히 배출되지 못하고 방광에 남아 있어 소변을 보는데 어려움을 느끼게 됩니다. 소변이 제대로 배출되지 못하면 방광이 과도하게 팽창하여 복부의 압통, 불편감 등의 증상을 유발할 수 있습니다.
소변의 색상이 이상하게 변하는 경우



방광암 초기증상으로 소변의 색상이 이상하게 변하는 경우는 방광벽에 생긴 종양이나 염증으로 인해 소변에 피가 섞이는 경우입니다. 이로 인해 소변의 색상이 붉거나 갈색조각이 나타날 수 있습니다. 그러나 이 증상이 항상 방광암의 초기증상은 아니며, 다른 원인에 의해 발생할 수도 있습니다.
소변을 보는데 긴장이 풀리지 않는 경우



방광암 초기증상으로 소변을 보는데 긴장이 풀리지 않는 경우는 방광암으로 인해 방광벽이 불완전하게 수축하거나, 방광에 종양이 생겨 긴장이 계속 유지되기 때문에 발생합니다. 이로 인해 방광에 소변이 충분히 채워지지 않아 소변의 배출이 어려워지며, 긴장 상태로 방광을 지속적으로 수축시키기 때문에 복부의 압통, 불편감 등의 증상이 나타날 수 있습니다.
발열이 동반되는 경우



방광암 초기증상으로 발열이 동반되는 경우는 방광암이 체내에 염증을 유발하여 발생할 수 있습니다. 방광벽이 염증으로 인해 부어오르거나 붓는 경우에는 발열이 동반될 수 있습니다. 그러나 이 증상이 항상 방광암의 초기증상은 아니며, 다른 원인에 의해 발생할 수도 있습니다.
비트 효능 10가지 자세히 알아보기
비트 효능 10가지 자세히 알아보기 레드 비트는 빨간색으로 된 원뿔 모양의 뿌리채소로, 비트로도 불립니다. 식탁에서 주로 생으로 씹거나 삶아서 먹거나 쥬스로 만들어서 마시는데, 당도가 높
wjdqhakstp.goodtory.kr
과민성 대장 증후군에 좋은 음식 10가지 자세히 알아보기
과민성 대장 증후군에 좋은 음식 10가지 자세히 알아보기
과민성 대장 증후군에 좋은 음식 10가지 자세히 알아보기 과민성 대장 증후군은 대장의 기능이 이상적으로 작동하지 않아 소화 과정에서 문제가 발생하는 식이 변동성 장질환입니다. 증상은 변
wjdqhakstp.goodtory.kr
양배추 효능 10가지 총정리
양배추 효능 10가지 총정리 양배추는 유럽에서 시작된 식물로, 국내에서는 봄부터 가을까지 재배되며 겨울철에는 저온다. 잎이 겹겹이 쌓여 있는 모습으로, 겉은 보라색, 안쪽은 연두색으로 되
wjdqhakstp.goodtory.kr
'건강생활' 카테고리의 다른 글
| 혈압 낮추는 법 10가지 자세히 알아보기 (0) | 2023.05.01 |
|---|---|
| 미역 효능 10가지 총정리 (0) | 2023.04.26 |
| 아보카도 효능 10가지 자세히 알아보기 (1) | 2023.04.24 |
| 키위 효능 10가지 자세히 알아보기 (0) | 2023.04.24 |
| 당근 효능 10가지 자세히 알아보기 (0) | 2023.04.20 |
댓글